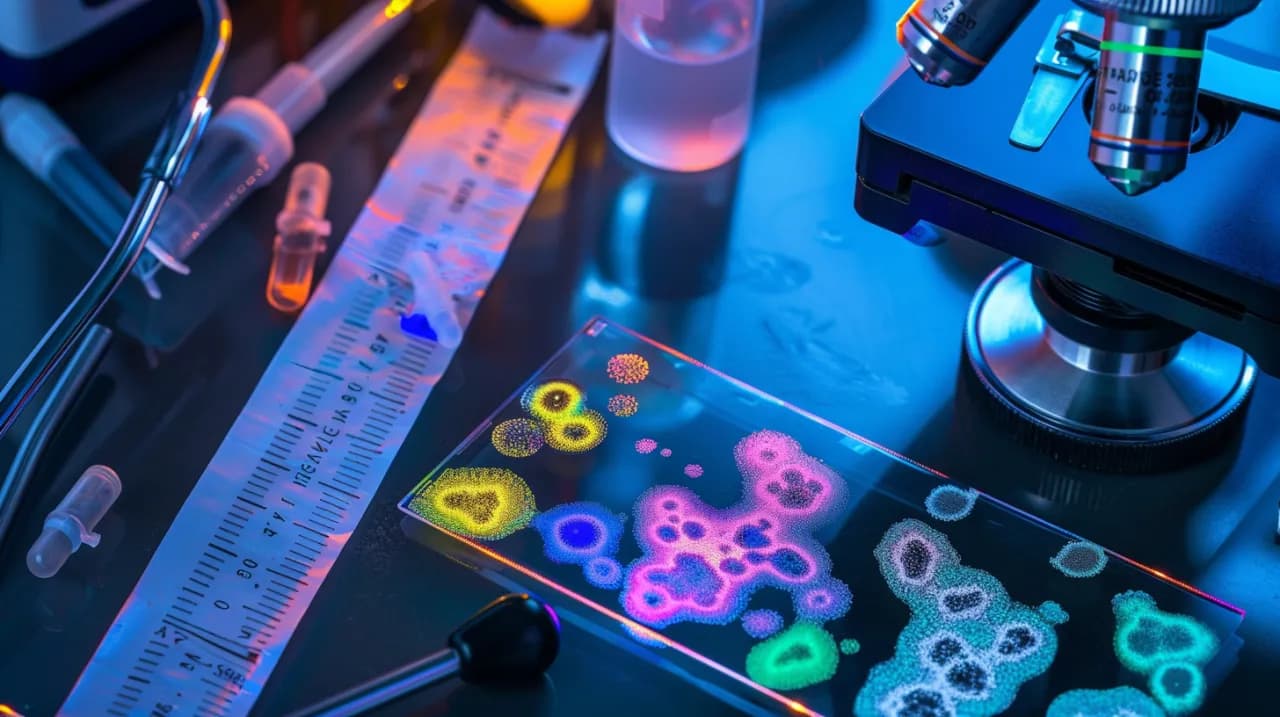
Czy wynik testu na Helicobacter pylori jest ujemny? Jak to sprawdzić

Wynik helikobakter może być kluczowy dla Twojego zdrowia. Zastanawiasz się, czy Twój test na Helicobacter pylori wyszedł ujemny? To ważne pytanie, które może mieć znaczący wpływ na Twoje samopoczucie i dalsze leczenie. W tym artykule dowiesz się, jak prawidłowo interpretować wyniki testu, jakie są metody sprawdzania obecności tej bakterii w organizmie oraz co robić, gdy masz wątpliwości co do rezultatu. Niezależnie od tego, czy jesteś pacjentem czy po prostu dbasz o swoje zdrowie, ta wiedza pomoże Ci lepiej zrozumieć sytuację i podjąć odpowiednie kroki.
Kluczowe wnioski:- Ujemny wynik testu na H. pylori oznacza brak wykrycia bakterii, ale nie zawsze wyklucza jej obecność.
- Istnieją różne metody testowania, w tym testy z krwi, kału i oddechowe - każda ma swoje zalety i ograniczenia.
- Objawy takie jak ustąpienie zgagi czy poprawa trawienia mogą sugerować ujemny wynik, ale nie są stuprocentowo pewne.
- W przypadku wątpliwości lub utrzymujących się objawów, warto rozważyć powtórzenie testu lub konsultację z lekarzem.
- Na wynik testu mogą wpływać różne czynniki, w tym niedawne stosowanie antybiotyków czy inhibitorów pompy protonowej.
Jak interpretować wynik helikobakter ujemny?
Interpretacja wyniku ujemnego helikobakter może być kluczowa dla Twojego zdrowia. Ujemny wynik testu oznacza, że w badanej próbce nie wykryto obecności bakterii Helicobacter pylori. To dobra wiadomość, ale pamiętaj, że nie zawsze jest to równoznaczne z całkowitym brakiem infekcji.
Czułość testów na H. pylori może się różnić w zależności od metody. Niektóre badania mogą nie wykryć bakterii, jeśli jej ilość jest niewielka lub znajduje się w trudno dostępnych miejscach żołądka. Dlatego ważne jest, aby wynik testu zawsze interpretować w kontekście objawów i historii medycznej.
Jeśli otrzymałeś wynik ujemny helikobakter, a mimo to nadal odczuwasz dolegliwości żołądkowe, nie ignoruj ich. Może to oznaczać, że test był fałszywie ujemny lub że Twoje objawy mają inne przyczyny. W takim przypadku warto skonsultować się z lekarzem, który może zalecić dodatkowe badania.
Pamiętaj, że pojedynczy ujemny wynik nie zawsze jest ostateczny. W niektórych przypadkach lekarze mogą zalecić powtórzenie testu lub wykonanie badania inną metodą, aby upewnić się, że wynik jest prawidłowy. To szczególnie ważne, jeśli masz objawy sugerujące infekcję H. pylori lub czynniki ryzyka jej wystąpienia.
Metody testowania wyników helikobakter w domu
Istnieje kilka metod testowania obecności bakterii Helicobacter pylori, które możesz wykonać w domowym zaciszu. Jedną z najpopularniejszych jest test z krwi. Polega on na pobraniu niewielkiej ilości krwi z palca i umieszczeniu jej na specjalnym pasku testowym. Wynik otrzymasz w ciągu kilku minut.
Inną metodą jest test z kału. W tym przypadku musisz pobrać próbkę kału i umieścić ją w specjalnym pojemniku. Następnie dodajesz do niej odczynnik i odczytujesz wynik. Ta metoda jest bardziej dokładna niż test z krwi, ale może być mniej komfortowa dla niektórych osób.
Test oddechowy to kolejna opcja, choć zazwyczaj wymaga wizyty w laboratorium. Polega on na wypiciu roztworu zawierającego mocznik znakowany izotopem węgla, a następnie analizie wydychanego powietrza. Jest to jedna z najdokładniejszych metod wykrywania aktywnej infekcji H. pylori.
Pamiętaj, że testy domowe, choć wygodne, mogą nie być tak dokładne jak badania laboratoryjne. Jeśli masz wątpliwości co do wyniku lub utrzymujące się objawy, zawsze warto skonsultować się z lekarzem.
Czytaj więcej: Badanie na krew utajoną w kale- kiedy warto gotować?
Objawy wskazujące na negatywny wynik helikobakter
Chociaż objawy nie są stuprocentowym wskaźnikiem wyniku ujemnego helikobakter, istnieją pewne sygnały, które mogą sugerować brak infekcji. Jednym z nich jest ustąpienie lub znaczne zmniejszenie się dolegliwości żołądkowych, takich jak ból brzucha, zgaga czy wzdęcia, szczególnie jeśli wcześniej podejrzewano infekcję H. pylori.
Poprawa apetytu i normalizacja masy ciała również mogą być dobrym znakiem. Osoby z infekcją H. pylori często doświadczają utraty wagi lub trudności z przybraniem na wadze. Jeśli zauważasz, że Twoja waga stabilizuje się lub wraca do normy, może to sugerować brak aktywnej infekcji.
Ustąpienie nudności i wymiotów to kolejny symptom, który może wskazywać na wynik ujemny helikobakter. Infekcja H. pylori często powoduje te nieprzyjemne objawy, więc ich brak może być pozytywnym sygnałem.
Pamiętaj jednak, że brak objawów nie zawsze oznacza brak infekcji. H. pylori może być obecna w organizmie bez wywoływania wyraźnych symptomów. Dlatego tak ważne jest regularne wykonywanie badań kontrolnych, szczególnie jeśli należysz do grupy podwyższonego ryzyka.
- Ustąpienie bólu brzucha i zgagi
- Poprawa apetytu i stabilizacja masy ciała
- Brak nudności i wymiotów
- Ogólna poprawa samopoczucia
- Normalizacja wypróżnień
Kiedy powtórzyć test na wynik helikobakter?
Decyzja o powtórzeniu testu na H. pylori powinna być podjęta w porozumieniu z lekarzem, ale istnieją sytuacje, w których warto rozważyć ponowne badanie. Jednym z głównych powodów jest utrzymywanie się objawów mimo wyniku ujemnego helikobakter. Jeśli nadal odczuwasz ból brzucha, zgagę czy inne dolegliwości żołądkowe, może to sugerować, że pierwszy test był fałszywie ujemny.
Innym powodem do powtórzenia testu jest zakończenie terapii przeciwko H. pylori. Lekarze często zalecają wykonanie testu kontrolnego 4-6 tygodni po zakończeniu leczenia, aby upewnić się, że bakteria została skutecznie wyeliminowana. Jest to szczególnie ważne, ponieważ H. pylori może rozwinąć oporność na antybiotyki.
Jeśli należysz do grupy wysokiego ryzyka, na przykład masz bliskiego krewnego z rakiem żołądka lub cierpisz na przewlekłe choroby żołądka, Twój lekarz może zalecić regularne powtarzanie testu, nawet jeśli poprzedni wynik był ujemny. To pomaga w szybkim wykryciu ewentualnej reinfekcji.
Pamiętaj, że niektóre czynniki mogą wpływać na dokładność testu. Jeśli przed pierwszym badaniem przyjmowałeś leki takie jak inhibitory pompy protonowej lub antybiotyki, mogło to zafałszować wynik. W takim przypadku lekarz może zalecić powtórzenie testu po odstawieniu tych leków na odpowiedni czas.
Czynniki wpływające na wynik helikobakter pylori
Istnieje wiele czynników, które mogą wpłynąć na wynik ujemny helikobakter, nawet jeśli bakteria jest obecna w organizmie. Jednym z najważniejszych jest stosowanie pewnych leków przed testem. Inhibitory pompy protonowej (IPP), często używane w leczeniu zgagi i choroby refluksowej, mogą znacząco zmniejszyć ilość bakterii H. pylori w żołądku, prowadząc do fałszywie ujemnego wyniku.
Antybiotyki to kolejny czynnik, który może zaburzyć wynik testu. Nawet jeśli nie były stosowane specyficznie przeciwko H. pylori, mogą czasowo zmniejszyć ilość bakterii poniżej progu wykrywalności testu. Dlatego ważne jest, aby poinformować lekarza o wszystkich przyjmowanych lekach przed wykonaniem badania.
Sposób pobrania i przechowywania próbki również ma znaczenie, szczególnie w przypadku testów z kału. Nieprawidłowe pobranie próbki lub jej przechowywanie w nieodpowiednich warunkach może prowadzić do degradacji bakterii i fałszywie ujemnego wyniku.
Warto pamiętać, że niektóre osoby mogą mieć naturalnie niższy poziom kolonizacji H. pylori, co może utrudnić wykrycie bakterii standardowymi testami. W takich przypadkach lekarz może zalecić wykonanie kilku różnych rodzajów testów, aby zwiększyć szansę na prawidłową diagnozę.
- Stosowanie inhibitorów pompy protonowej (IPP) przed testem
- Niedawne przyjmowanie antybiotyków
- Nieprawidłowe pobranie lub przechowywanie próbki
- Naturalnie niski poziom kolonizacji H. pylori
- Czas wykonania testu w stosunku do ostatniego posiłku
Konsultacja lekarska a wynik helikobakter ujemny
Nawet jeśli otrzymałeś wynik ujemny helikobakter, konsultacja z lekarzem może być niezbędna. Specjalista może pomóc w interpretacji wyniku w kontekście Twoich objawów i historii medycznej. Pamiętaj, że ujemny wynik testu nie zawsze oznacza brak problemu – mogą istnieć inne przyczyny Twoich dolegliwości.
Lekarz może zasugerować dodatkowe badania, takie jak gastroskopia, aby wykluczyć inne schorzenia żołądka czy przełyku. To szczególnie ważne, jeśli objawy utrzymują się mimo ujemnego wyniku testu na H. pylori. Czasami konieczne może być powtórzenie testu inną metodą lub po odstawieniu pewnych leków.
Podczas konsultacji lekarz może również omówić z Tobą czynniki ryzyka infekcji H. pylori i doradzić, jak minimalizować ryzyko zarażenia w przyszłości. To dobra okazja, aby porozmawiać o Twoim stylu życia i diecie, które mogą wpływać na zdrowie Twojego układu pokarmowego.
Pamiętaj, że lekarz jest Twoim partnerem w dbaniu o zdrowie. Nie wahaj się zadawać pytań i dzielić swoimi wątpliwościami. Im lepiej zrozumiesz swój stan zdrowia i wyniki badań, tym łatwiej będzie Ci podejmować świadome decyzje dotyczące swojego zdrowia.
Podsumowanie
Wynik ujemny helikobakter to dobra wiadomość, ale wymaga właściwej interpretacji. Ważne jest, aby rozumieć, że pojedynczy test nie zawsze daje pełny obraz sytuacji. Różne czynniki mogą wpływać na wynik, dlatego kluczowa jest obserwacja objawów i konsultacja z lekarzem.
Regularne badania i świadomość czynników ryzyka pomagają w skutecznej kontroli zdrowia. Nawet przy wyniku ujemnym helikobakter, utrzymujące się dolegliwości żołądkowe powinny skłonić do dalszej diagnostyki. Pamiętajmy, że zdrowie układu pokarmowego to nie tylko kwestia obecności lub braku bakterii H. pylori.